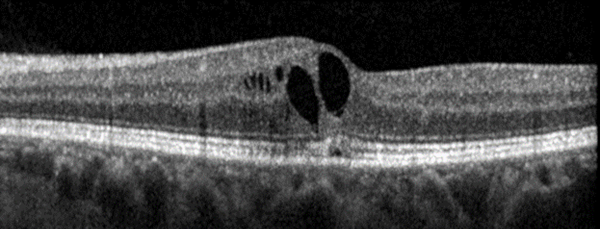

Diagnosis and discussion
Diagnosis
Epiretinal membrane OU
Differential diagnoses
Differential Diagnosis (at least 5)
While the appearance of epiretinal membrane is distinctive, particularly on imaging, other ocular conditions can present with similar visual symptoms, and some may be associated with ERM. These include:
Macular Hole
Macular hole is a defect in the retina at the macula. Due to its location at the macula, the portion of the retina responsible for central vision, patients can present with metamorphopsia (central vision distortion) or loss of central vision. While the clinical features of macular hole are in line with the symptoms endorsed by this patient, the examination and imaging findings on OCT are inconsistent with macular hole. See the example below of macular hole on OCT.

Macular Edema
As with other conditions listed here, the location of macular edema can lead to metamorphopsia, decreased visual acuity, and other central vision changes. However, this patient does not have a history of vascular conditions that would predispose her to the development of macular edema, such as diabetes or retinal vein occlusion. While she does have a history of cystoid macular edema (CME), her current imaging does not demonstrate significant edema. An example of chronic CME seen on OCT is pictured below.
Age-related Macular Degeneration
Age-related Macular Degeneration is a common disease, especially in aging patients, that affects the retina by way of various changes which in some cases can be worsened by the formation of new blood vessels, known as neovascularization. The involvement of the macula can eventually lead to symptoms including metamorphopsia, blurry vision, and central scotoma or blind spot depending on disease severity.1 Characteristic clinical features on examination include drusen, which are yellow deposits beneath the level of the retinal pigment epithelium (RPE), pigment changes, and retinal atrophy.2
Posterior Vitreous Detachment
Posterior Vitreous Detachment (PVD) occurs when the posterior vitreous separates from the retina due to normal aging changes in the vitreous humor.3 Much like with ERM, patients with PVD can be largely asymptomatic. Additionally, if the PVD involves the macula, patients can present with symptoms similar to ERM, and PVD can even lead to the development of other conditions such as macular hole. Patients can also present with photopsia and floaters. This patient currently lacks examination findings consistent with PVD.
Central Serous Chorioretinopathy
Central Serous Chorioretinopathy is a disease affecting the retina, often by way of subretinal fluid that most commonly accumulates near the macula. As established above, this can present with clinical features similar to those in patients with symptomatic ERM. It is associated with a wide array of possible OCT findings, such as serous retinal detachment, RPE disruption, and outer retinal atrophy.5 This patient lacks any of these imaging findings on OCT at this time.
Retinal Detachment
Retinal detachment should be ruled out in patients with changes in visual acuity. Clinically, patients can present with vision loss, photopsia, and increased floaters in their vision. Retinal detachment would be very unlikely to result in central visual disturbance with preserved peripheral vision. The lack of suggestive features of retinal detachment on history, exam, or imaging makes this diagnosis unlikely.
Definition
An epiretinal membrane (ERM) is a layer of cells that have proliferated abnormally either idiopathically or due to existing ocular disease.5 The membrane is located on the anterior retinal surface. ERMs are often asymptomatic but can lead to visually significant symptoms depending on their location and severity. For example, if the membrane involves the central macula/fovea, patients can present with decreased visual acuity, metamorphopsia – often seen as “wavy lines”, decreased contrast sensitivity and visual acuity, and loss of depth perception. This condition is particularly common in older individuals, and increasing age is the biggest risk factor for developing ERM. Most patients who present with ERM are over 50 years of age.5
Examination
Neovascular glaucoma is a clinical diagnosis made by examining the patient with a slit lamp and gonioscopy, as well as utilizing ancillary imaging techniques, which may include fluorescein angiography, ultrasound (A-scan, B-scan, and UBM), OCT, and fundus photography.3-5,7,13 Patients may be asymptomatic during the early stages of NVG; however, during later stages, they may present with various symptoms, including a red eye, tearing, ocular pain, decreased vision, light sensitivity, seeing halos around lights, and/or nausea and vomiting.2

Examination/Diagnostics
Examination
As noted above, conditions such as retinal detachment should be ruled out during the patient examination to prevent serious vision loss. As such, a careful and thorough assessment should include visual acuity measurements, slit lamp examination, and dilated fundus examination to rule out retinal tears and/or detachments. Of note, these conditions are not mutually exclusive, as ERM can occur secondary to retinal tears or prior retinal detachment.5 On dilated fundus exam, an ERM can have a “shimmering” appearance and can also cause distortion of retinal vessels due to tractional forces.6
Diagnostics
In addition to suggestive examination findings, imaging is also useful in diagnosing ERM. In fact, optical coherence tomography is considered the gold standard for diagnosis, and when combined with appropriate clinical exam, has been shown to have enhanced sensitivity over examination alone.5 OCT can provide additional information about factors that may aid in the prediction of postoperative visual prognosis, such as severity classification, area involved, and depth of traction.5 Notably, findings on OCT that are associated with worse visual prognosis include disruption of outer retinal layers, inner retinal irregularity, and persistent inner retinal layers extending across the fovea (known as ectopic inner foveal layers).5
Treatment
Current preferred treatment for ERM consists of vitreoretinal surgery. Progression of disease is typically slow, if it occurs at all. In fact, in a study following ERM patients for 5 years, most did not progress in severity, and some ERMs even regressed or resolved during that time. As many ERM patients are asymptomatic it is acceptable to simply monitor the condition over time, particularly if patients do not feel their symptoms affect their quality of life. In these cases, surgery remains an option if patients begin to experience visually significant symptoms or daily activities become affected.5 When considering surgical intervention, it is important to note that patients with better preoperative visual acuity tend to have better postoperative acuity, but patients with worse preoperative acuity show a greater degree of improvement after surgery.7